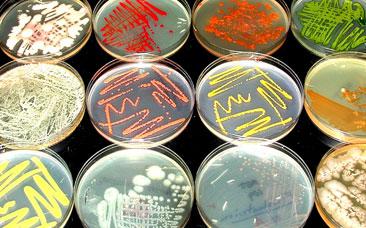
Rows of petri dishes on a table

The microbes constitute the vast majority of organisms in the biosphere and are the foundation on which all life depends. Microbiological research currently underway in the Department of Biological Sciences includes studies of the organization and evolution of bacterial genomes and studies into the life cycles and evolutionary history of bacteriophages.
The microbes constitute the vast majority of organisms in the biosphere and are the foundation on which all life depends. Microbiological research currently underway in the Department of Biological Sciences includes studies of the organization and evolution of bacterial genomes and studies into the life cycles and evolutionary history of bacteriophages.
 Jon P. Boyle |  Laty Cahoon |
 |  Graham Hatfull |
 Kevin Kohl |  Jeffrey Lawrence |
 Tera Levin |  James Pipas |
 Corinne Richards-Zawacki |
